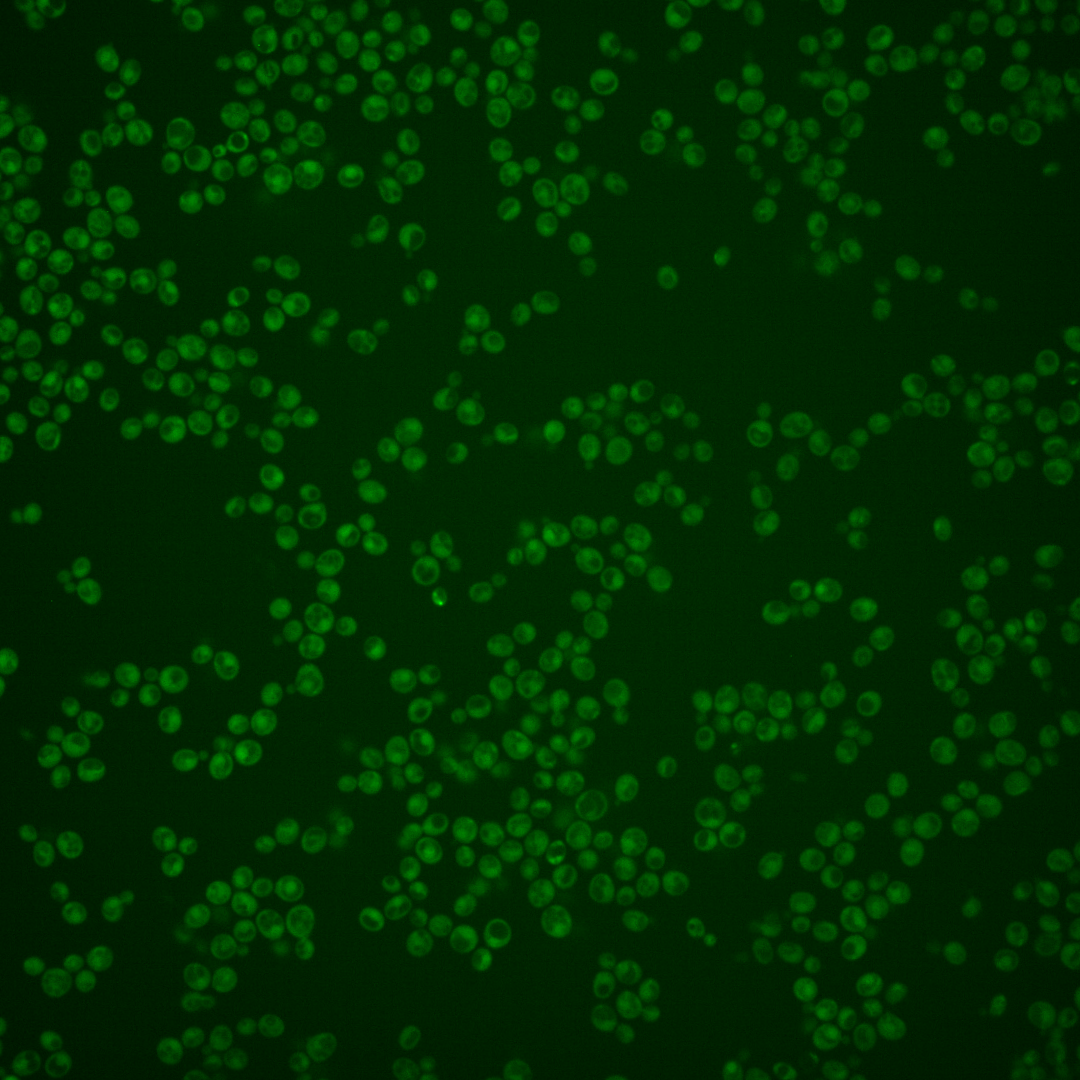
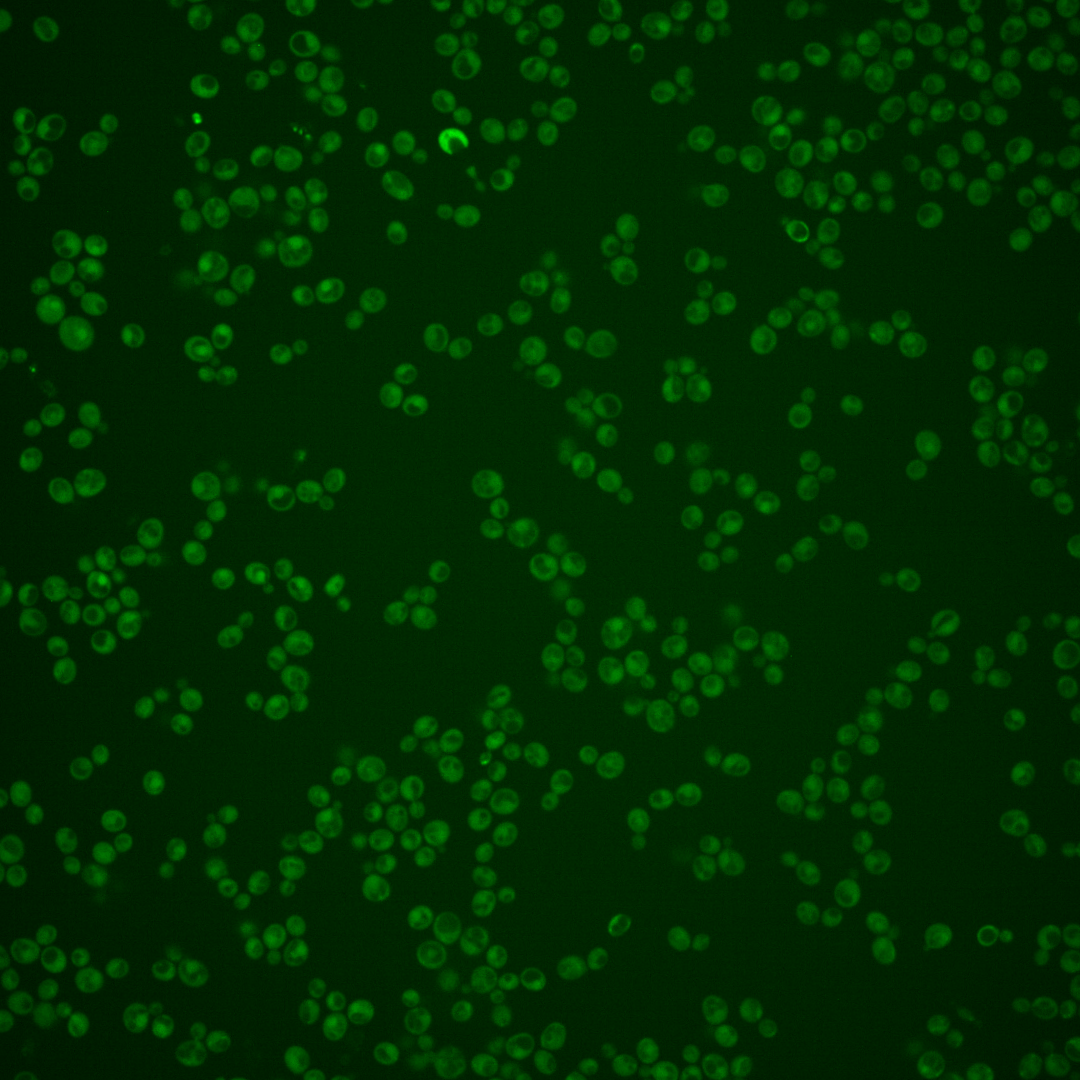
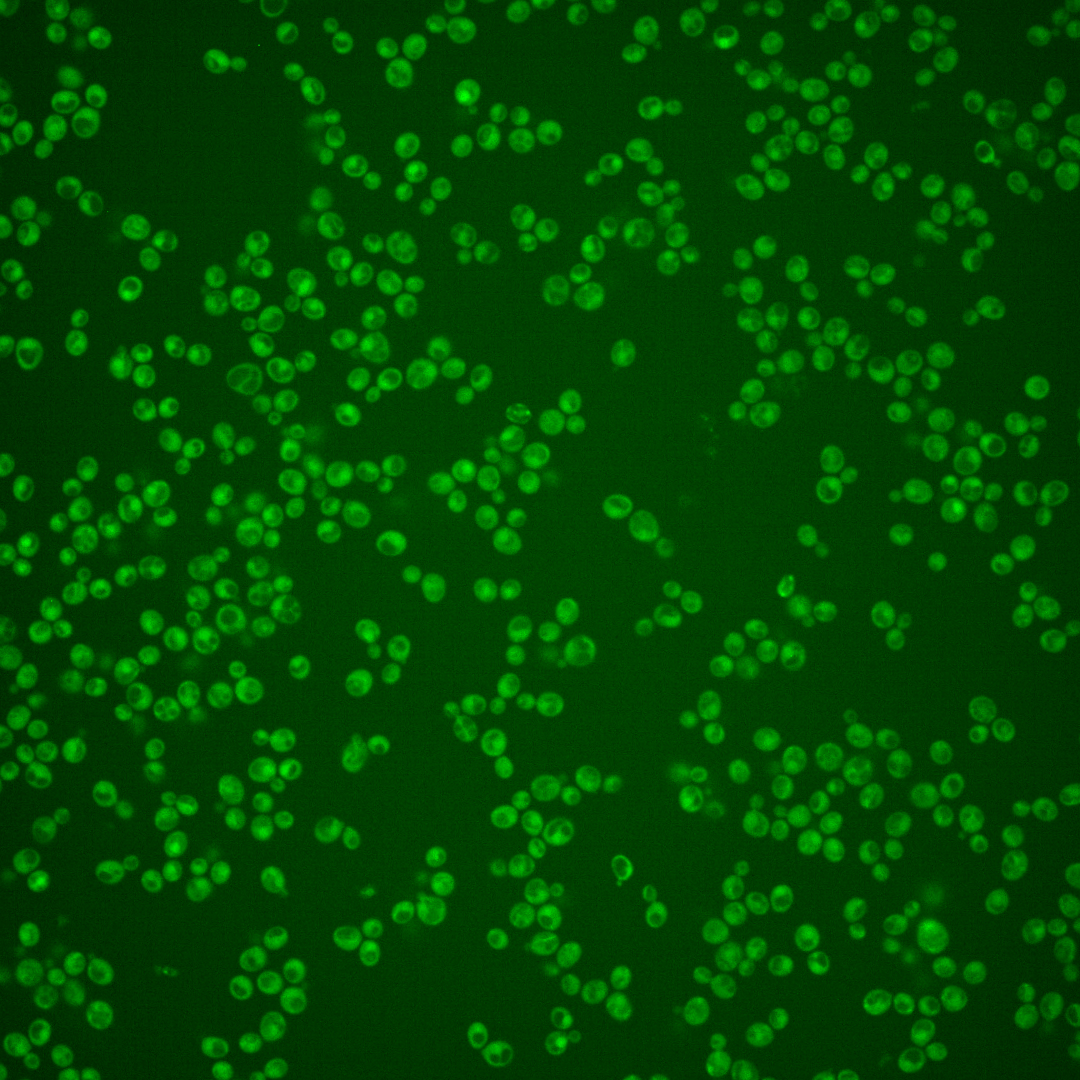
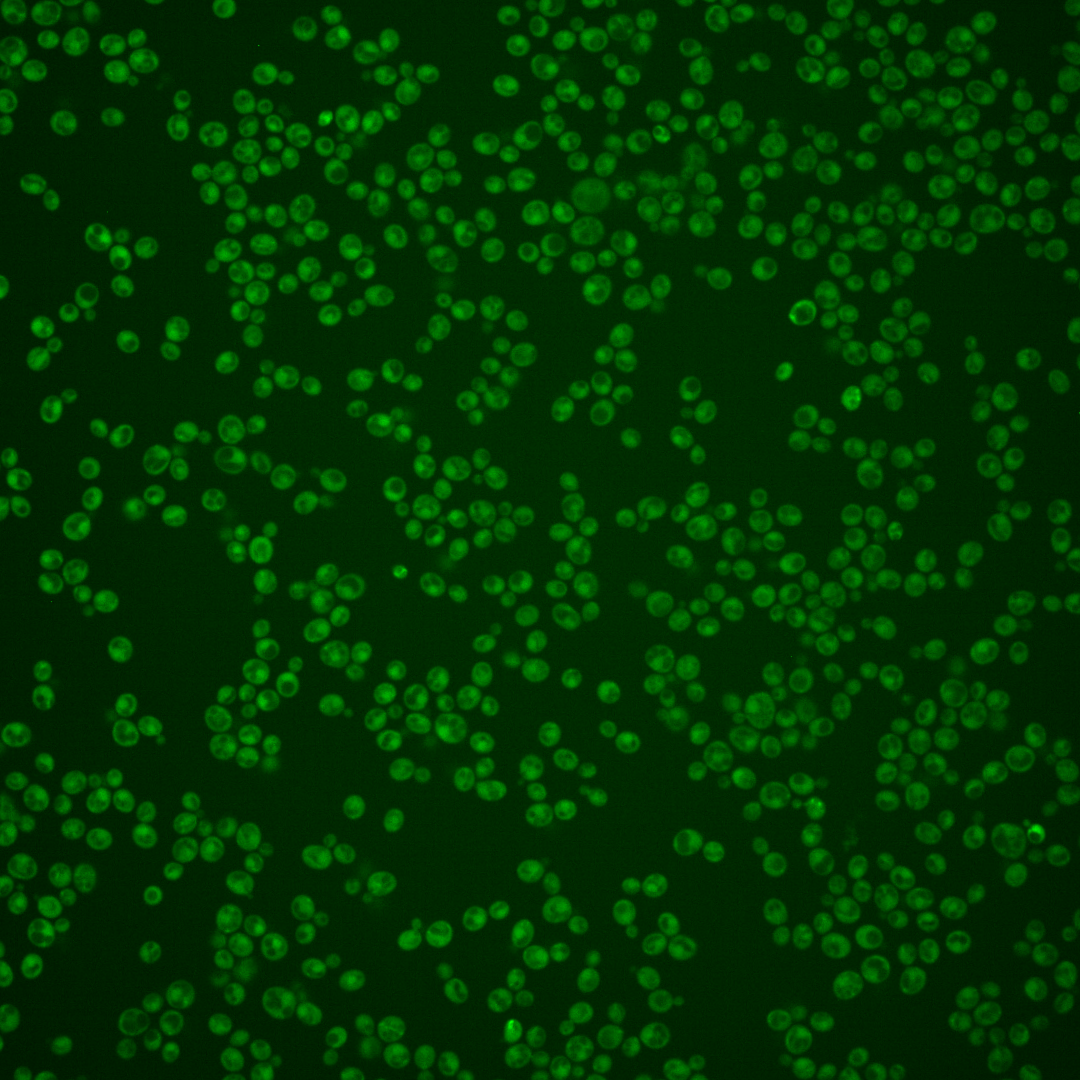
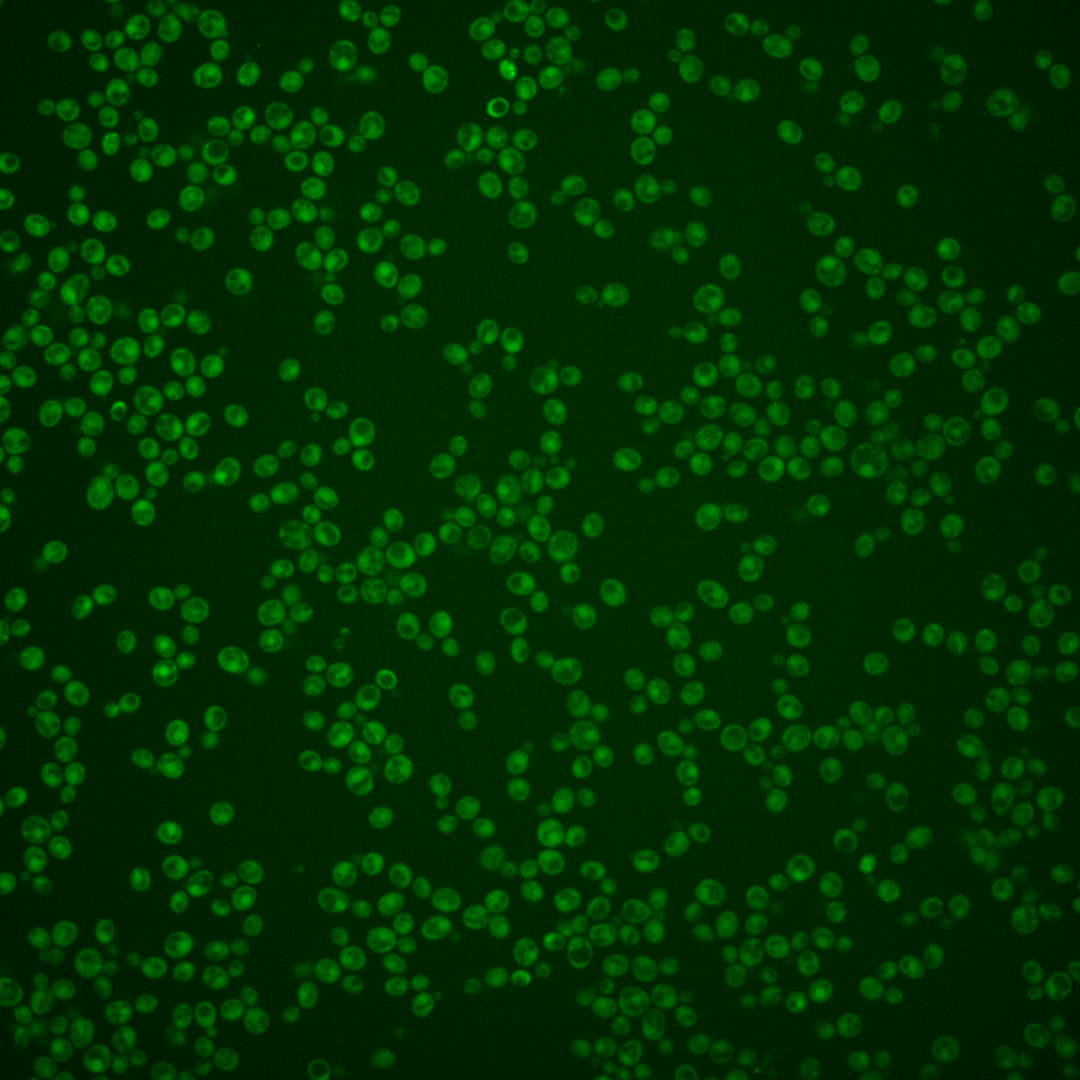
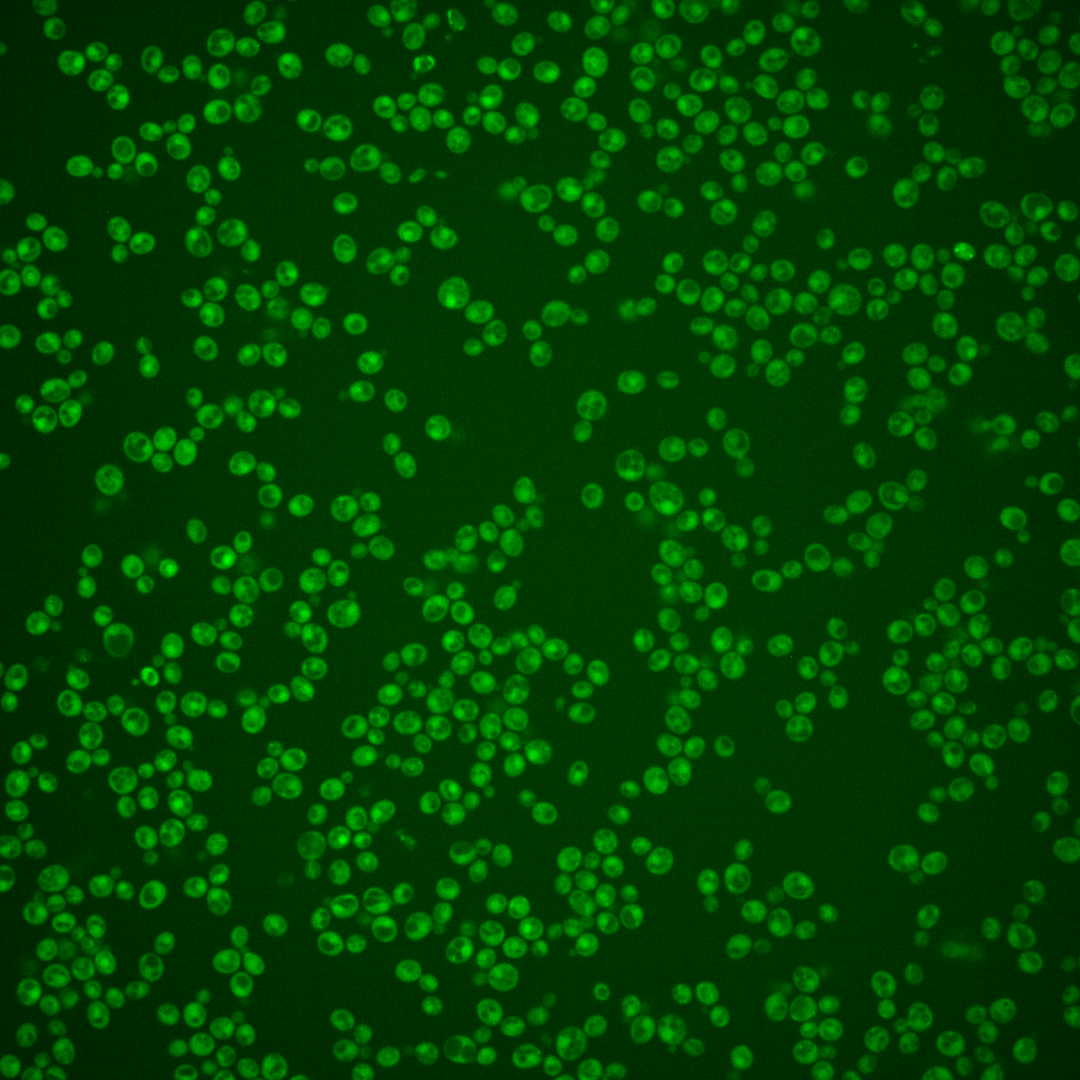

| Standard name | |
|---|---|
| Human Ortholog | |
| Description | Component of the RSC chromatin remodeling complex; essential gene required for maintenance of proper ploidy and regulation of ribosomal protein genes and the cell wall/stress response; RSC3 has a paralog, RSC30, that arose from the whole genome duplication |
Micrographs




















































































Sub-cellular Localization
Yeast GFP Assignment
Protein Abundance
Localization Change
External localization resources
| ensLOC | DeepLoc | |||||||||||||||||||||||
|---|---|---|---|---|---|---|---|---|---|---|---|---|---|---|---|---|---|---|---|---|---|---|---|---|
| Localization | WT1 | WT2 | WT3 | RAP60 | RAP140 | RAP220 | RAP300 | RAP380 | RAP460 | RAP540 | RAP620 | RAP700 | HU80 | HU120 | HU160 | rpd3Δ_1 | rpd3Δ_2 | rpd3Δ_3 | WT1 | WT2 | WT3 | AF100 | AF140 | AF180 |
| Cortical Patches | 0 | 0 | 0 | 0 | 0 | 0 | 1 | 0 | 0 | 0 | 0 | 2 | 0 | 0 | 0 | 0 | 0 | – | 3 | 2 | 3 | 8 | 10 | 8 |
| Bud | 0 | 2 | 0 | 0 | 1 | 0 | 1 | 1 | 4 | 4 | 8 | 1 | 1 | 0 | 0 | 0 | 0 | – | 2 | 3 | 2 | 2 | 9 | 18 |
| Bud Neck | 1 | 0 | 10 | 8 | 13 | 1 | 16 | 13 | 6 | 8 | 6 | 13 | 0 | 0 | 0 | 0 | 0 | – | 1 | 0 | 1 | 3 | 5 | 5 |
| Bud Site | 0 | 0 | 0 | 0 | 0 | 0 | 0 | 0 | 0 | 0 | 1 | 2 | 0 | 0 | 1 | 0 | 0 | – | – | – | – | – | – | – |
| Cell Periphery | 0 | 2 | 4 | 5 | 1 | 0 | 1 | 0 | 1 | 2 | 0 | 0 | 0 | 0 | 0 | 3 | 0 | – | 0 | 1 | 4 | 5 | 7 | 6 |
| Cytoplasm | 247 | 239 | 299 | 270 | 285 | 245 | 424 | 382 | 279 | 275 | 140 | 181 | 381 | 478 | 472 | 105 | 115 | – | 209 | 201 | 208 | 252 | 269 | 285 |
| Endoplasmic Reticulum | 1 | 2 | 1 | 1 | 1 | 0 | 0 | 0 | 0 | 0 | 0 | 0 | 1 | 0 | 2 | 10 | 9 | – | 3 | 0 | 0 | 4 | 3 | 5 |
| Endosome | 0 | 0 | 0 | 0 | 0 | 0 | 1 | 0 | 0 | 0 | 0 | 0 | 1 | 0 | 0 | 0 | 0 | – | 4 | 8 | 2 | 2 | 3 | 1 |
| Golgi | 0 | 0 | 0 | 0 | 0 | 1 | 0 | 0 | 0 | 0 | 0 | 0 | 0 | 0 | 0 | 1 | 1 | – | 1 | 2 | 0 | 1 | 1 | 1 |
| Mitochondria | 4 | 10 | 0 | 1 | 0 | 11 | 31 | 27 | 80 | 81 | 68 | 63 | 3 | 2 | 1 | 7 | 3 | – | 16 | 25 | 33 | 58 | 67 | 59 |
| Nucleus | 0 | 0 | 2 | 1 | 2 | 0 | 2 | 8 | 2 | 4 | 0 | 6 | 0 | 1 | 2 | 0 | 2 | – | 0 | 0 | 2 | 0 | 0 | 0 |
| Nuclear Periphery | 0 | 0 | 0 | 0 | 0 | 0 | 0 | 0 | 0 | 0 | 0 | 0 | 0 | 0 | 0 | 0 | 0 | – | 0 | 0 | 0 | 0 | 1 | 0 |
| Nucleolus | 0 | 0 | 0 | 0 | 0 | 0 | 0 | 0 | 0 | 0 | 0 | 0 | 0 | 0 | 0 | 0 | 0 | – | 0 | 0 | 0 | 0 | 1 | 0 |
| Peroxisomes | 0 | 1 | 0 | 0 | 0 | 0 | 0 | 0 | 0 | 0 | 0 | 0 | 0 | 0 | 0 | 0 | 0 | – | 0 | 0 | 0 | 0 | 0 | 0 |
| SpindlePole | 0 | 0 | 4 | 2 | 1 | 1 | 4 | 2 | 7 | 2 | 6 | 7 | 0 | 1 | 1 | 0 | 1 | – | 3 | 2 | 7 | 2 | 9 | 6 |
| Vac/Vac Membrane | 0 | 3 | 1 | 0 | 0 | 4 | 6 | 2 | 0 | 3 | 0 | 1 | 0 | 1 | 0 | 4 | 7 | – | 5 | 5 | 4 | 14 | 16 | 13 |
| Unique Cell Count | 251 | 252 | 305 | 274 | 290 | 254 | 450 | 403 | 322 | 317 | 186 | 233 | 384 | 481 | 477 | 112 | 123 | 257 | 263 | 283 | 369 | 420 | 422 | |
| Labelled Cell Count | 253 | 259 | 321 | 288 | 304 | 263 | 487 | 435 | 379 | 379 | 229 | 276 | 387 | 483 | 479 | 130 | 138 | 257 | 263 | 283 | 369 | 420 | 422 | |
Yeast GFP Assignment
Protein Abundance
| Screen | WT1 | WT2 | WT3 | RAP60 | RAP140 | RAP220 | RAP300 | RAP380 | RAP460 | RAP540 | RAP620 | RAP700 | HU80 | HU120 | HU160 | rpd3Δ_1 | rpd3Δ_2 | rpd3Δ_3 | AF100 | AF140 | AF180 |
|---|---|---|---|---|---|---|---|---|---|---|---|---|---|---|---|---|---|---|---|---|---|
| Mean Cell GFP Intensity (1e-4) | 3.8 | 3.9 | 4.9 | 4.4 | 4.7 | 4.9 | 3.7 | 4.2 | 3.1 | 3.2 | 3.0 | 3.5 | 3.6 | 3.8 | 3.8 | 6.0 | 5.9 | – | 3.6 | 3.6 | 4.0 |
| Std Deviation (1e-4) | 0.9 | 1.0 | 2.6 | 2.4 | 1.6 | 5.4 | 1.4 | 2.0 | 1.4 | 1.4 | 1.5 | 1.2 | 1.1 | 1.3 | 0.9 | 1.9 | 2.1 | – | 1.4 | 1.6 | 2.0 |
| Intensity Change (Log2) | – | – | – | -0.17 | -0.08 | -0.0 | -0.43 | -0.24 | -0.65 | -0.63 | -0.73 | -0.5 | -0.46 | -0.37 | -0.38 | 0.28 | 0.26 | – | -0.45 | -0.44 | -0.29 |
Localization Change
| Localization | RAP60 | RAP140 | RAP220 | RAP300 | RAP380 | RAP460 | RAP540 | RAP620 | RAP700 | HU80 | HU120 | HU160 | rpd3Δ_1 | rpd3Δ_2 | rpd3Δ_3 |
|---|---|---|---|---|---|---|---|---|---|---|---|---|---|---|---|
| Actin | – | – | – | – | – | – | – | – | – | – | – | – | – | – | – |
| Bud | – | – | – | – | – | – | – | – | – | – | – | – | – | – | – |
| Bud Neck | – | – | – | – | – | – | – | – | – | – | – | – | – | – | – |
| Bud Site | – | – | – | – | – | – | – | – | – | – | – | – | – | – | – |
| Cell Periphery | – | – | – | – | – | – | – | – | – | – | – | – | – | – | – |
| Cyto | – | – | – | – | – | – | – | – | – | – | – | – | – | – | – |
| Endoplasmic Reticulum | – | – | – | – | – | – | – | – | – | – | – | – | – | – | – |
| Endosome | – | – | – | – | – | – | – | – | – | – | – | – | – | – | – |
| Golgi | – | – | – | – | – | – | – | – | – | – | – | – | – | – | – |
| Mitochondria | – | – | – | – | – | – | – | – | – | – | – | – | – | – | – |
| Nuclear Periphery | – | – | – | – | – | – | – | – | – | – | – | – | – | – | – |
| Nuc | – | – | – | – | – | – | – | – | – | – | – | – | – | – | – |
| Nucleolus | – | – | – | – | – | – | – | – | – | – | – | – | – | – | – |
| Peroxisomes | – | – | – | – | – | – | – | – | – | – | – | – | – | – | – |
| SpindlePole | – | – | – | – | – | – | – | – | – | – | – | – | – | – | – |
| Vac | – | – | – | – | – | – | – | – | – | – | – | – | – | – | – |
| Cortical Patches | – | – | – | – | – | – | – | – | – | – | – | – | – | – | – |
| Cytoplasm | – | – | – | – | – | – | – | – | – | – | – | – | – | – | – |
| Nucleus | – | – | – | – | – | – | – | – | – | – | – | – | – | – | – |
| Vacuole | – | – | – | – | – | – | – | – | – | – | – | – | – | – | – |
External localization resources
Images






























Protein Concentration and Protein Localization Data
| R1 | R2 | R3 | ||||||||||||||||
|---|---|---|---|---|---|---|---|---|---|---|---|---|---|---|---|---|---|---|
| G1 Pre-START | G1 Post-START | S/G2 | Metaphase | Anaphase | Telophase | G1 Pre-START | G1 Post-START | S/G2 | Metaphase | Anaphase | Telophase | G1 Pre-START | G1 Post-START | S/G2 | Metaphase | Anaphase | Telophase | |
| Concentration | 0.8222 | 1.1172 | 0.7908 | 2.0054 | 0.4275 | 0.9733 | -1.0975 | -0.7453 | -0.8875 | -1.1008 | -0.662 | -0.8634 | -1.3105 | -0.918 | -1.1054 | -0.3705 | -0.7248 | -1.0977 |
| Actin | 0.0145 | 0.0001 | 0.0019 | 0.0332 | 0.0365 | 0.0067 | 0.0255 | 0.003 | 0.0102 | 0 | 0.0033 | 0.005 | 0.0247 | 0.0004 | 0.0109 | 0.0527 | 0.0117 | 0.0045 |
| Bud | 0.0007 | 0.0011 | 0.0004 | 0.0006 | 0.0007 | 0.0007 | 0.0012 | 0.0029 | 0.0051 | 0.0006 | 0.0007 | 0.0012 | 0.0093 | 0.0401 | 0.0353 | 0.0028 | 0.0156 | 0.0213 |
| Bud Neck | 0.0007 | 0.0001 | 0.0005 | 0.0112 | 0.0007 | 0.0004 | 0.0012 | 0.0002 | 0.001 | 0.0001 | 0.0002 | 0.0007 | 0.0005 | 0.0008 | 0.0011 | 0.0007 | 0.0006 | 0.0053 |
| Bud Periphery | 0.0014 | 0.0003 | 0.0013 | 0.0011 | 0.0011 | 0.0034 | 0.0027 | 0.0047 | 0.002 | 0.0008 | 0.0029 | 0.002 | 0.0059 | 0.0113 | 0.0151 | 0.0023 | 0.0121 | 0.0122 |
| Bud Site | 0.002 | 0.0052 | 0.0025 | 0.0297 | 0.0019 | 0.0001 | 0.0056 | 0.007 | 0.0097 | 0.0002 | 0.001 | 0.0008 | 0.0098 | 0.0476 | 0.0199 | 0.001 | 0.0024 | 0.0036 |
| Cell Periphery | 0.0004 | 0.0001 | 0.0005 | 0.0009 | 0.0001 | 0.0001 | 0.0004 | 0.0002 | 0.0003 | 0 | 0.0002 | 0.0001 | 0.0006 | 0.001 | 0.0006 | 0.0002 | 0.0003 | 0.0006 |
| Cytoplasm | 0.0229 | 0.0187 | 0.0151 | 0.0081 | 0.0124 | 0.0292 | 0.0347 | 0.0279 | 0.0301 | 0.0202 | 0.0149 | 0.059 | 0.0256 | 0.0285 | 0.0251 | 0.0304 | 0.0253 | 0.0883 |
| Cytoplasmic Foci | 0.0133 | 0.0153 | 0.0073 | 0.0276 | 0.0149 | 0.0079 | 0.0355 | 0.0165 | 0.0061 | 0.0044 | 0.011 | 0.0109 | 0.0355 | 0.008 | 0.0358 | 0.0087 | 0.0076 | 0.0263 |
| Eisosomes | 0.0016 | 0.0002 | 0.0009 | 0.0004 | 0.0004 | 0.0001 | 0.0004 | 0.0003 | 0.0002 | 0.0001 | 0.0002 | 0.0001 | 0.0005 | 0.0002 | 0.0003 | 0.0005 | 0.0003 | 0.0002 |
| Endoplasmic Reticulum | 0.0023 | 0.0002 | 0.0007 | 0.0087 | 0.0002 | 0.0002 | 0.0047 | 0.0006 | 0.0009 | 0.0001 | 0.0009 | 0.0007 | 0.0015 | 0.0005 | 0.0024 | 0.0009 | 0.0017 | 0.0015 |
| Endosome | 0.0154 | 0.0001 | 0.0059 | 0.0212 | 0.0024 | 0.0036 | 0.016 | 0.0078 | 0.0054 | 0.0002 | 0.0792 | 0.0073 | 0.0036 | 0.0002 | 0.0015 | 0.0036 | 0.0118 | 0.0023 |
| Golgi | 0.0064 | 0 | 0.0019 | 0.0104 | 0.0098 | 0.0013 | 0.0059 | 0.001 | 0.0017 | 0 | 0.0162 | 0.0077 | 0.0046 | 0.0001 | 0.0011 | 0.0158 | 0.005 | 0.0008 |
| Lipid Particles | 0.0422 | 0.0003 | 0.0094 | 0.0454 | 0.0014 | 0.0081 | 0.0193 | 0.0038 | 0.001 | 0.0001 | 0.005 | 0.0102 | 0.008 | 0.0002 | 0.0026 | 0.0057 | 0.0161 | 0.0034 |
| Mitochondria | 0.0066 | 0.0002 | 0.0074 | 0.0076 | 0.0053 | 0.0013 | 0.017 | 0.0133 | 0.0016 | 0.0001 | 0.0237 | 0.003 | 0.0073 | 0.0025 | 0.0073 | 0.0385 | 0.0065 | 0.0038 |
| None | 0.809 | 0.9545 | 0.9308 | 0.6839 | 0.9013 | 0.926 | 0.773 | 0.8872 | 0.9056 | 0.9721 | 0.8192 | 0.8729 | 0.815 | 0.7967 | 0.7559 | 0.8079 | 0.8311 | 0.7459 |
| Nuclear Periphery | 0.0062 | 0.0001 | 0.0011 | 0.0026 | 0.0001 | 0.0006 | 0.0017 | 0.0006 | 0.0005 | 0.0001 | 0.0005 | 0.0014 | 0.0016 | 0.0015 | 0.0024 | 0.0021 | 0.0065 | 0.0045 |
| Nucleolus | 0.0029 | 0.001 | 0.0019 | 0.0216 | 0.0006 | 0.0001 | 0.0007 | 0.0007 | 0.0011 | 0.0001 | 0.0002 | 0.0002 | 0.0034 | 0.0042 | 0.0067 | 0.0013 | 0.0026 | 0.0034 |
| Nucleus | 0.0082 | 0.0006 | 0.0016 | 0.0029 | 0.0003 | 0.0002 | 0.001 | 0.0008 | 0.0023 | 0.0002 | 0.0003 | 0.0012 | 0.0026 | 0.0269 | 0.0254 | 0.0062 | 0.0267 | 0.0244 |
| Peroxisomes | 0.0176 | 0.0001 | 0.0026 | 0.0756 | 0.0082 | 0.0084 | 0.0473 | 0.0149 | 0.0094 | 0 | 0.0025 | 0.0136 | 0.0244 | 0.0002 | 0.0023 | 0.0041 | 0.0033 | 0.0023 |
| Punctate Nuclear | 0.0232 | 0.0018 | 0.0043 | 0.0017 | 0.0016 | 0.0013 | 0.0021 | 0.0034 | 0.003 | 0.0001 | 0.0002 | 0.0012 | 0.0135 | 0.0279 | 0.0462 | 0.0133 | 0.0087 | 0.0428 |
| Vacuole | 0.0016 | 0.0002 | 0.0016 | 0.0045 | 0.0002 | 0.0001 | 0.0033 | 0.002 | 0.0023 | 0.0004 | 0.0143 | 0.0006 | 0.0015 | 0.001 | 0.0015 | 0.0009 | 0.003 | 0.0019 |
| Vacuole Periphery | 0.0007 | 0 | 0.0004 | 0.0012 | 0.0001 | 0.0001 | 0.0009 | 0.0014 | 0.0006 | 0 | 0.0035 | 0.0004 | 0.0006 | 0.0002 | 0.0004 | 0.0005 | 0.0012 | 0.0006 |
Sequencing Data
| R1 | R2 | |||||||||
|---|---|---|---|---|---|---|---|---|---|---|
| G1 Post-START | S/G2 | Metaphase | Anaphase | Telophase | G1 Post-START | S/G2 | Metaphase | Anaphase | Telophase | |
| Gene Expression | 24.4924 | 22.6369 | 19.2759 | 27.4308 | 22.0674 | 21.5746 | 24.9519 | 26.844 | 26.6367 | 31.2955 |
| Translational Efficiency | 0.8605 | 0.8572 | 0.9953 | 0.6149 | 0.8869 | 0.8162 | 0.7792 | 0.6462 | 0.7161 | 0.6365 |
Hit Data
| Dataset | Hit |
|---|---|
| Protein Concentration | ✔ |
| Protein Localization | ✘ |
| Gene Expression | ✘ |
| Translational Efficiency | ✘ |
Endocytosis
| Temp | Actin Patch (Sac6-tdTomato) | Cortical Patch (Sla1-GFP) | Late Endosome (Snf7-GFP) | Vacuole (Vph1-GFP) |
|---|---|---|---|---|
| 37℃ | ||||
| RT |
Cell Cycle Omics
CYCLoPs (Rsc3-GFP)
| Gene / Allele | Actin Patch (Sac6-tdTomato) | Cortical Patch (Sla1-GFP) | Late Endosome (Snf7-GFP) | Vacuole (Sac6-tdTomato) |
|---|
| Gene | Images |
|---|
| Gene | Images |
|---|
Images are not yet available
Images are not yet available